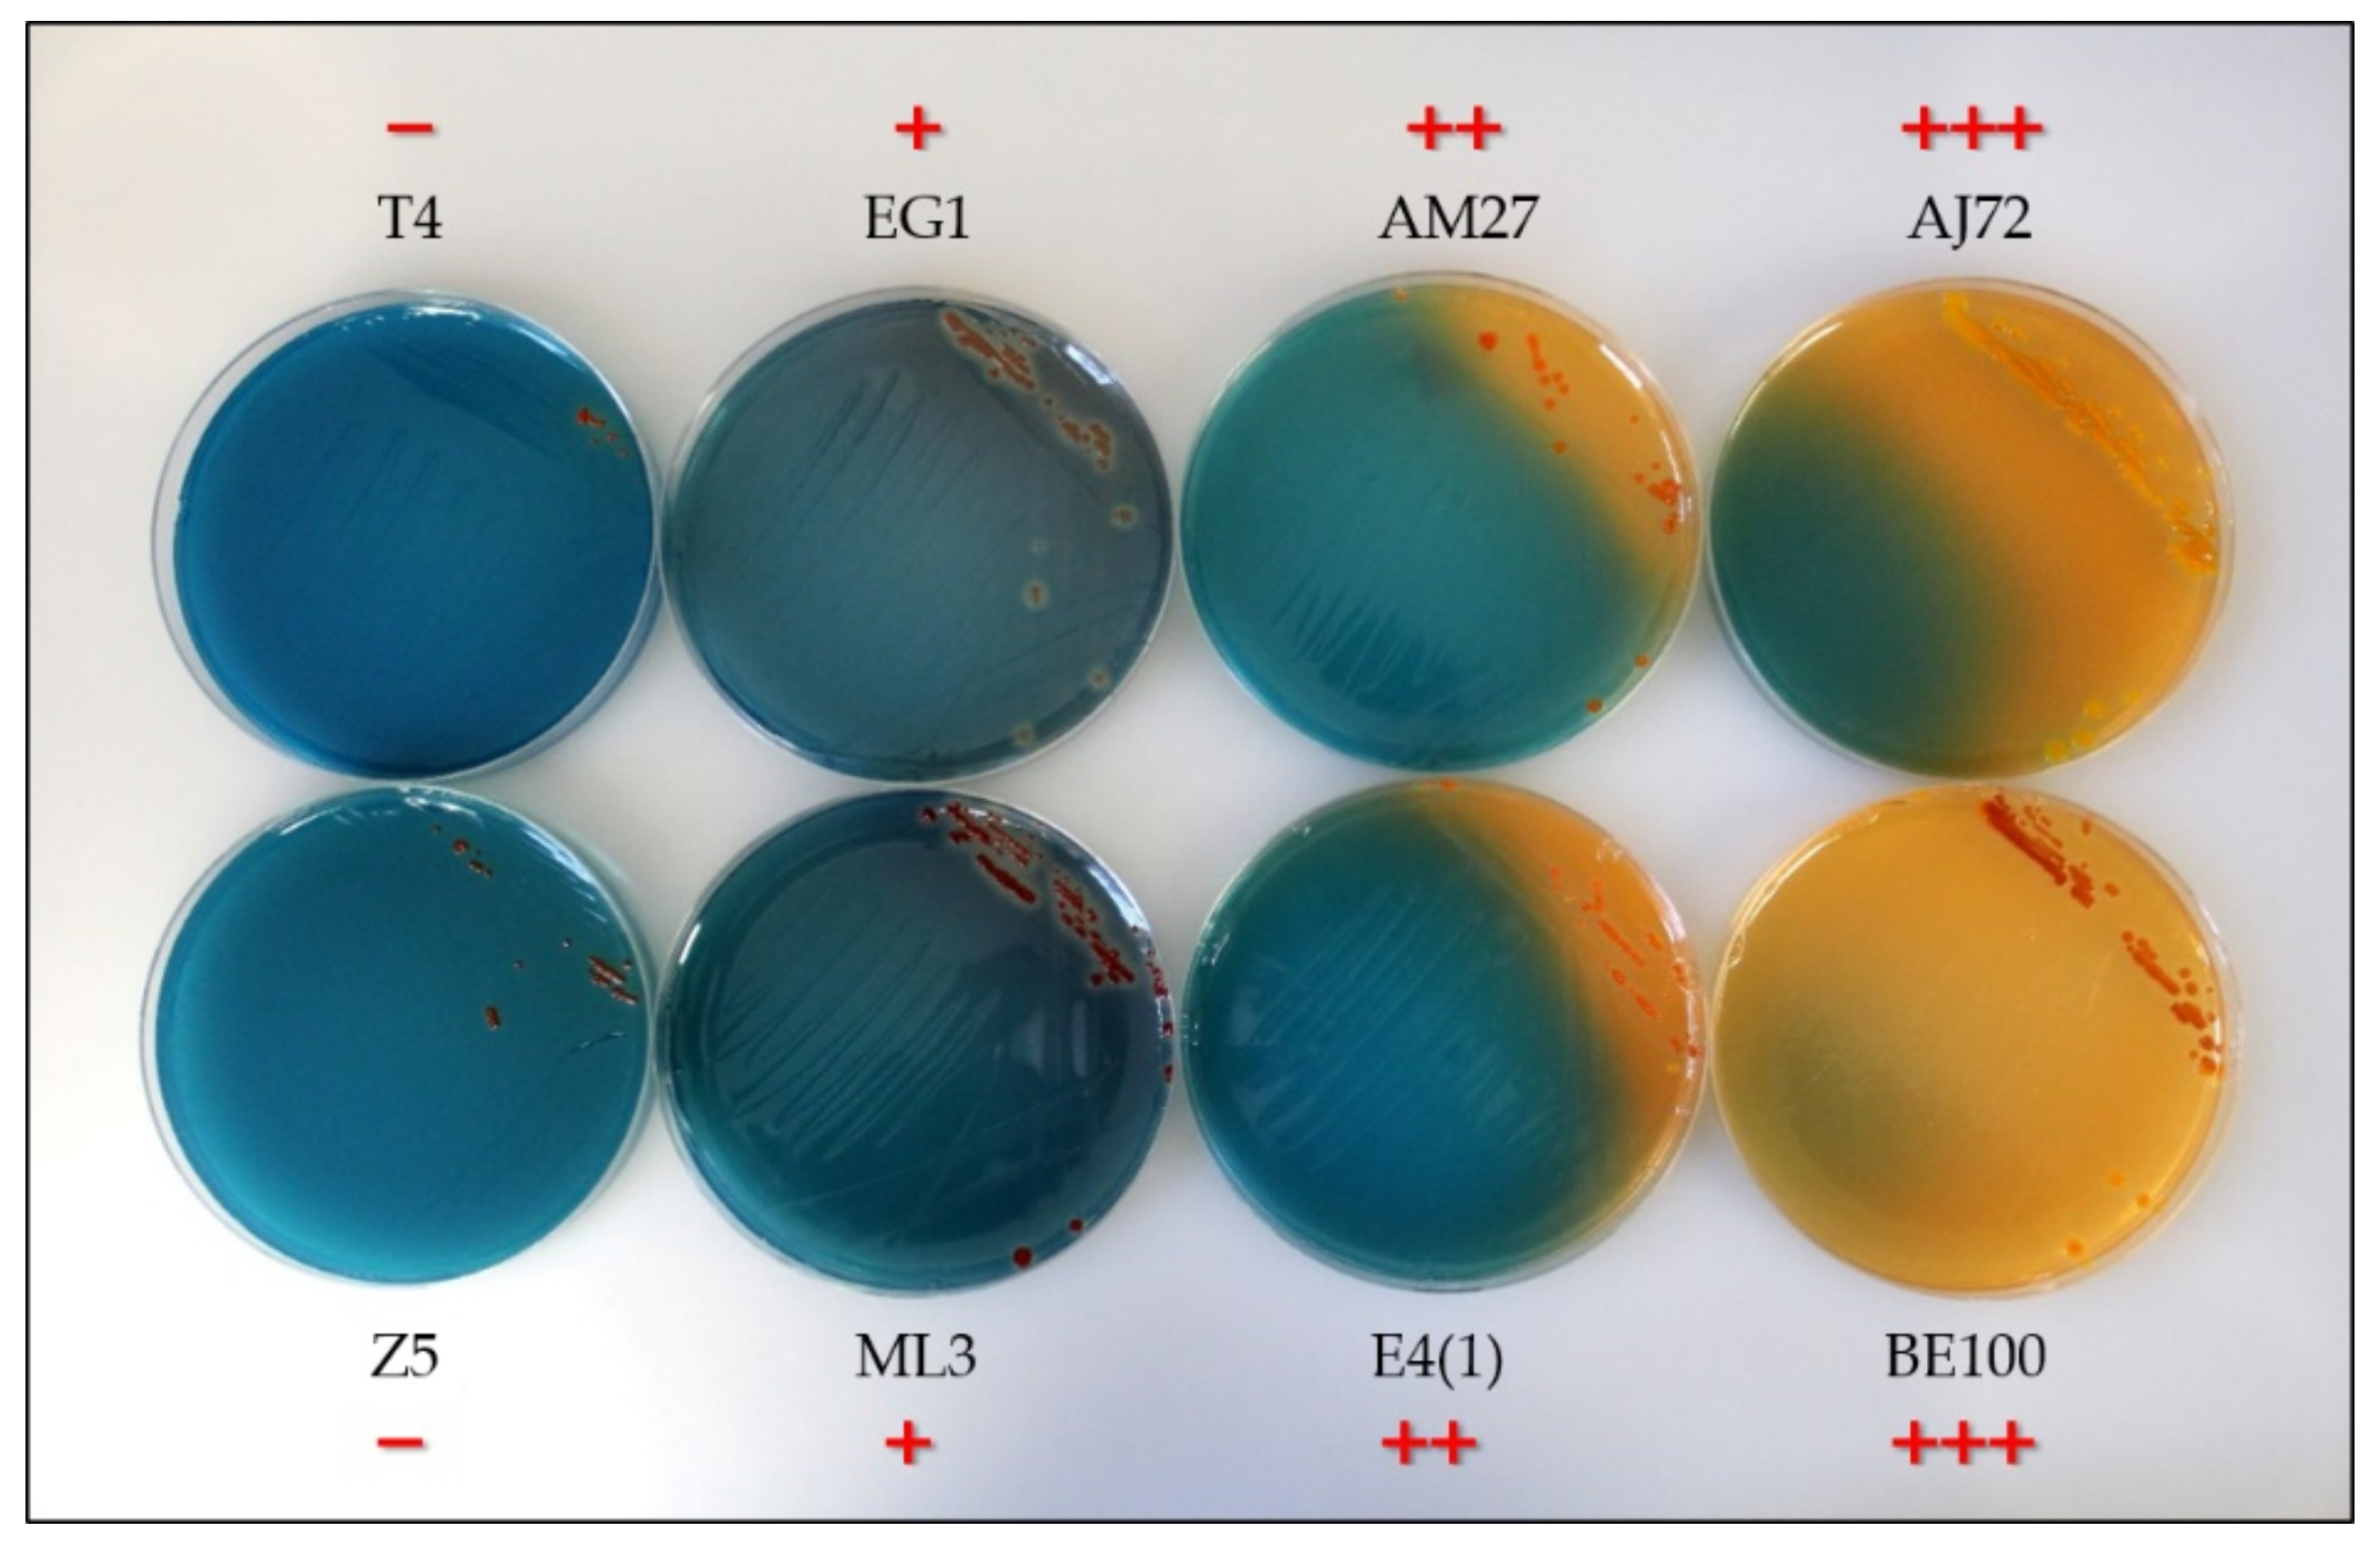
Microorganisms 09 00959 g0a1
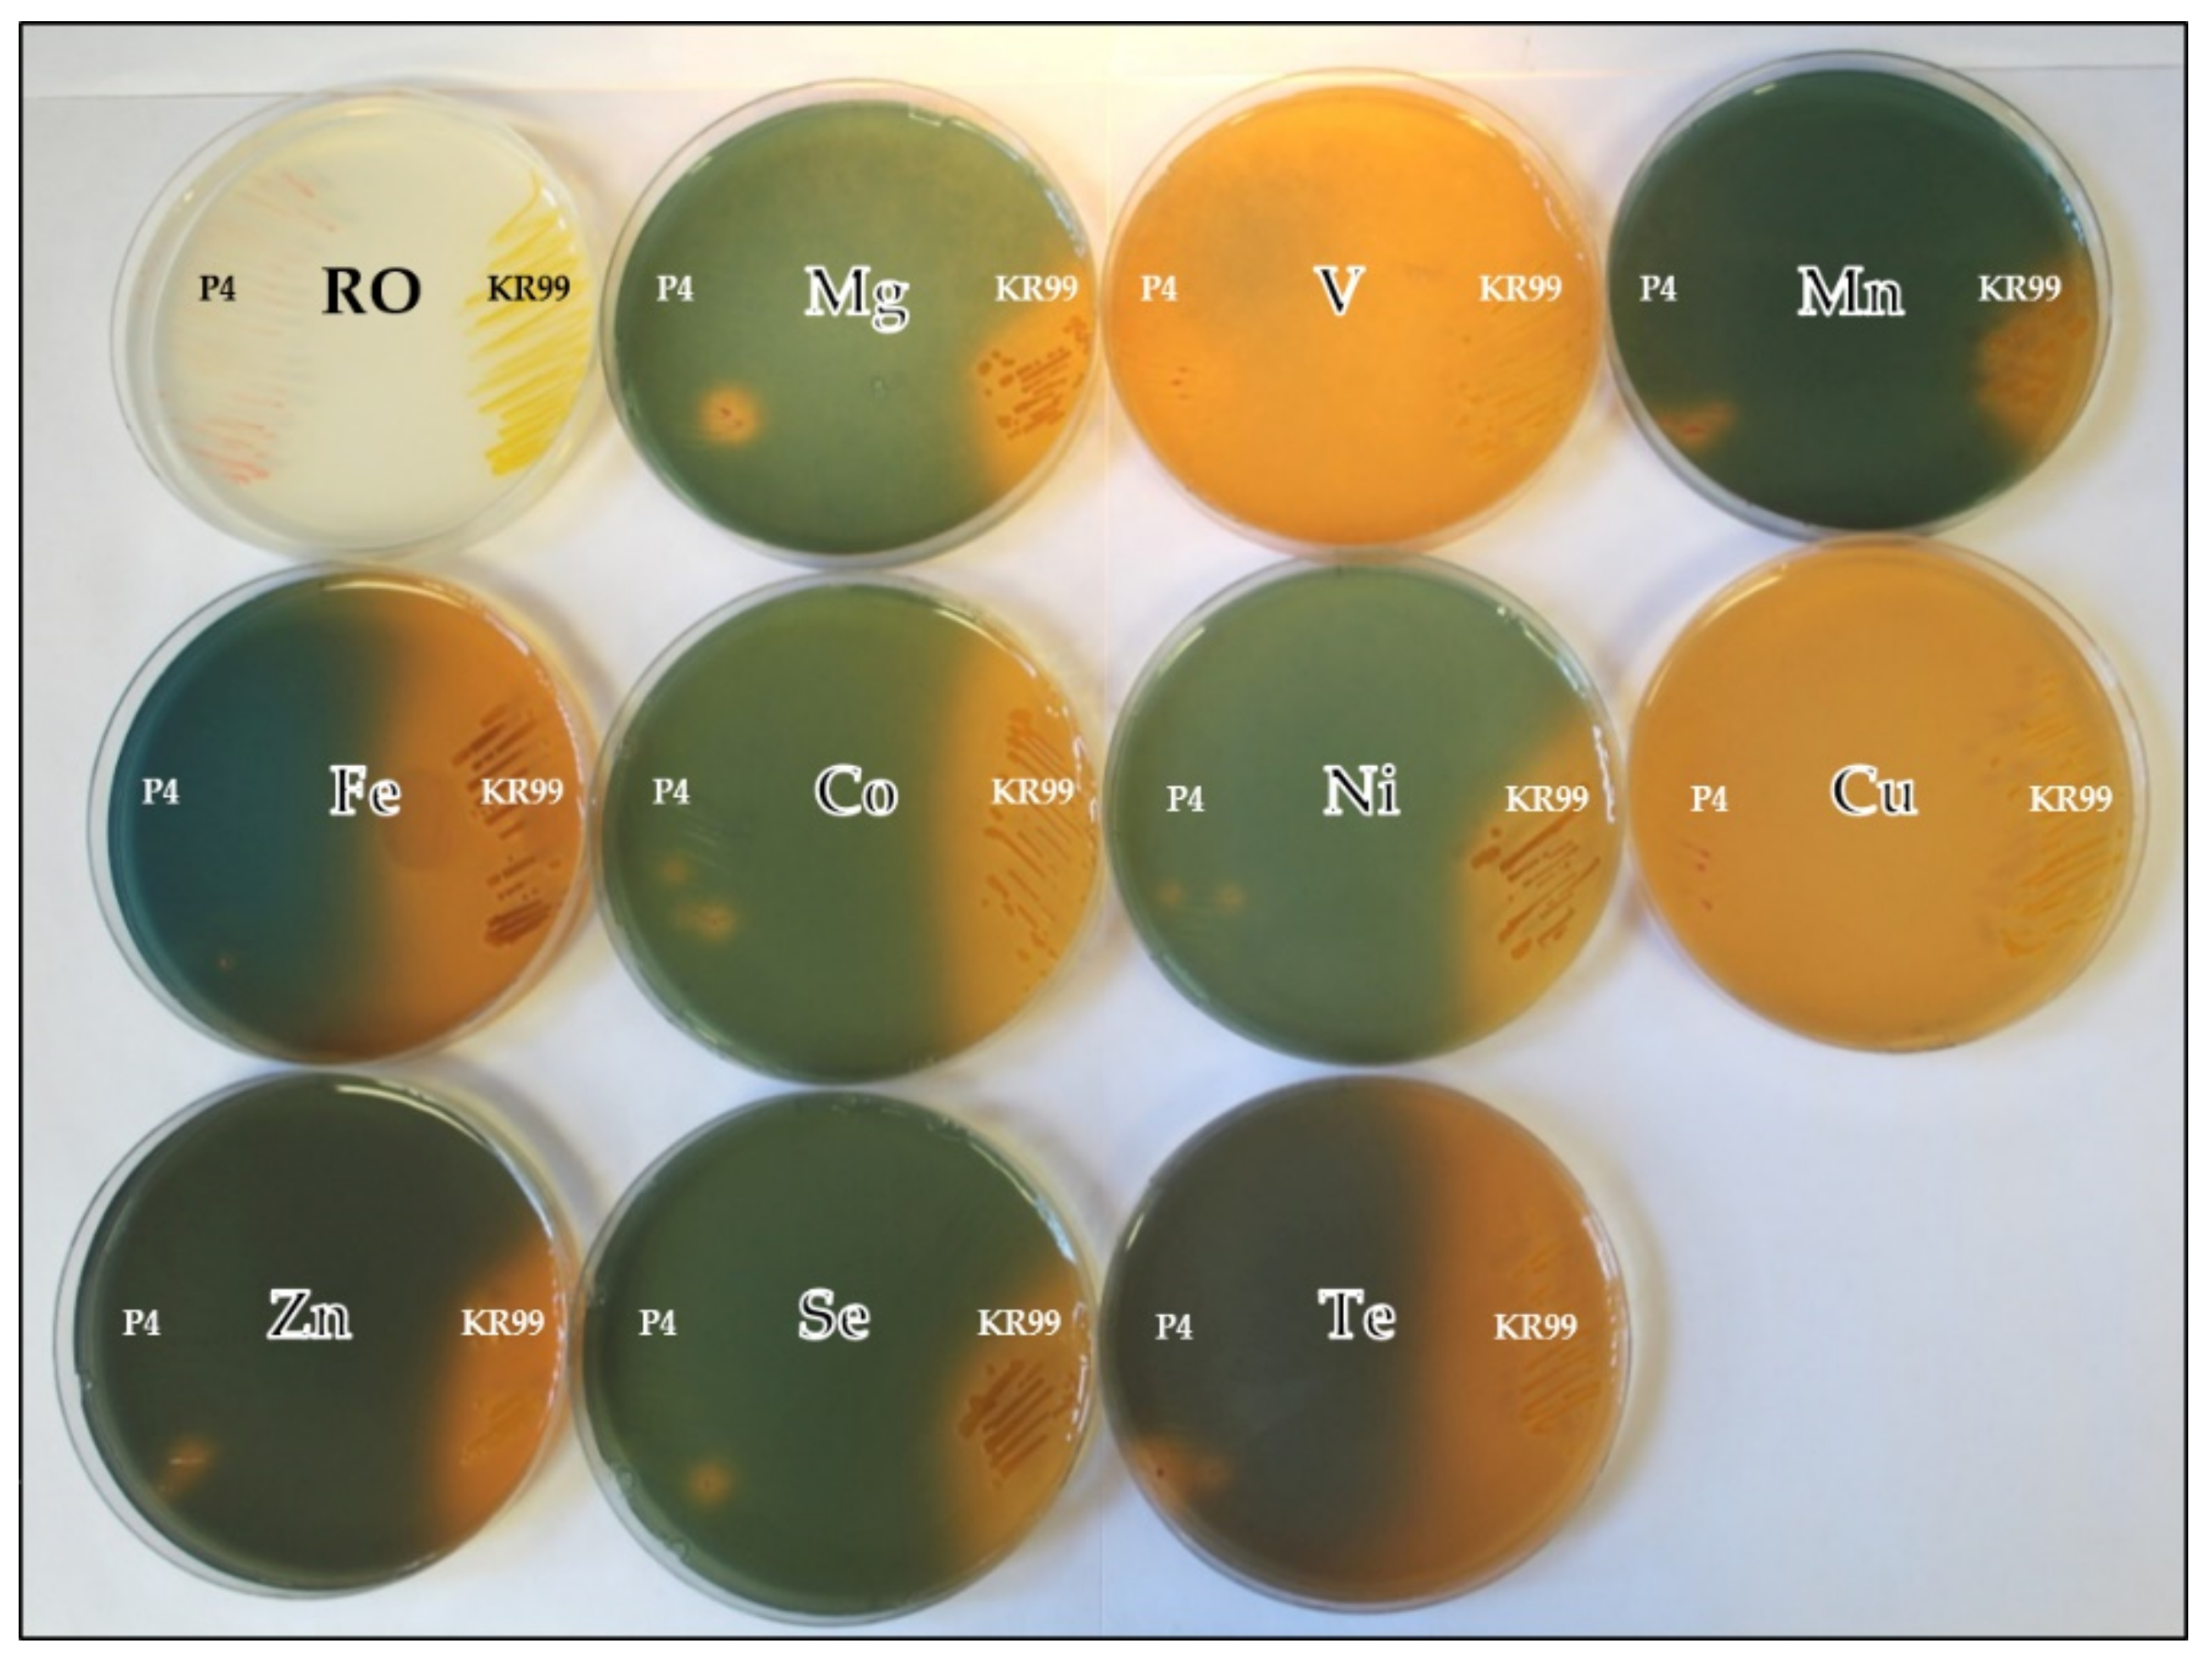
Microorganisms 09 00959 g0a2

Discovery of Siderophore and Metallophore Production in the Aerobic Anoxygenic Phototrophs
Abstract
1. Introduction
2. Materials and Methods
2.1. Bacterial Strains and Growth Conditions
2.2. Iron Chelating Chromeazurol S Assay
2.3. Variant Cation Chromeazurol S Assay
2.4. Phylogeny
2.5. Siderophore Isolation and Concentration from C. halotolerans
2.6. Purification and Fe-Chelation of Siderophore from C. halotolerans
3. Results
3.1. Bacterial Growth and Fe-CAS-Plate Reactions
3.2. Substitute Cation CAS Assays
3.3. Phylogenetic Diversity of Siderophore Producing AAP
3.4. C. halotolerans Pigment Purification and Identification
4. Discussion
4.1. Siderophore Production Revealed by CAS-Assay
4.2. Environmental Distribution of Siderophore Producers
4.3. Phylogenetic Diversity of Fe-Chelating AAP
4.4. Analysis of the Brown-Coloured Siderophore
5. Conclusions
Supplementary Materials
Author Contributions
Funding
Institutional Review Board Statement
Informed Consent Statement
Data Availability Statement
Conflicts of Interest
Appendix A

| Environment | Strain | Medium | Most Related Type Species | Accession # |
|---|---|---|---|---|
| Hot spring, Kamchatka island | KR99T | RO | Erythromonas ursincola | NR_119243.1 |
| Warm temperature spring, Bikal Lake, Russia | E1 | RO | 99.6% Porphyrobacter colymbi | MW970346 |
| E4(1) | RO | 99.7% Porphyrobacter donghaensis | MW970347 | |
| E5T | RO | Erythromicrobium ramosum | NR_041891.1 | |
| RB3T | RO | Roseococcus thiosulfatophilus | NR_026114.1 | |
| RB16-17T | RO | Sandaracinobacter sibiricus | NR_026382.1 | |
| T4T | RO-NaCl | Erythrobacter litoralis | NR_119016.1 | |
| Deep Ocean, Juan DeFuco Ridge, Pacific Ocean | JF1T | RO-NaCl | Citromicrobium bathyomarinum | Y16267.1 |
| C6 | RO-NaCl | 98.1% Citromicrobium bathyomarinum | MW970348 | |
| C7 | RO-NaCl | 99.8%Citromicrobium bathyomarinum | MW970349 | |
| C8 | RO-NaCl | 99.9%Citromicrobium bathyomarinum | MW970350 | |
| C14 | RO-NaCl | 99.6% Citromicrobium bathyomarinum | MW970351 | |
| C23 | RO-NaCl | 99.7% Citromicrobium bathyomarinum | MW970352 | |
| C26 | RO-NaCl | 99.8% Citromicrobium bathyomarinum | MW970353 | |
| N25 | RO-NaCl | 99.7% Citromicrobium bathyomarinum | MW970354 | |
| N34 | RO-NaCl | 99.7% Citromicrobium bathyomarinum | MW970355 | |
| N48 | RO-NaCl | 99.8% Citromicrobium bathyomarinum | MW970356 | |
| N56 | RO-NaCl | 99.9% Citromicrobium bathyomarinum | MW970357 | |
| N78 | RO-NaCl | 99.6% Citromicrobium bathyomarinum | MW970358 | |
| Rag Beach sediment, BC, Canada | 23-SB | RO-NaCl | 99.7% Porphyrobacter donghaensis | MW970359 |
| 15-SB | RO-NaCl | 99.8% Porphyrobacter donghaensis | MW970360 | |
| Central Gold Mine, MB, Canada | C4 | RO | 99.4% Porphyrobacter colymbi | KX148515 |
| C9 | RO | 99.1% Brevundimonas variabilis | KX148516 | |
| C11 | RO | 98.6% Brevundimonas bacteroides | KX148517 | |
| NM4.16 | RO | 99.7% Porphyrobacter colymbi | KX148518 | |
| NM4.18 | RO | 99.3% Blastomonas fulva | KX148519 | |
| Lake Winnipeg, MB, Canada | AJ 72 | RO | 99.7% Sphingorhabdus lacus | MW970361 |
| AM 19 | RO | 99.7% Erythromicrobium ramosum | MW970362 | |
| AM 27 | RO | 99.6% Erythromicrobium ramosum | MW970363 | |
| CK 182 | RO | 93.4% Porphyrobacter donghaensis | MW970364 | |
| BL 67 | RO | 98.9% Sandarakinorhabdus cyanobacteriorum | MW970365 | |
| BK 61 | RO | 99.1% Blastomonas fulva | MW970366 | |
| BE 100 | RO | 99.4% Porphyrobacter colymbi | MW970367 | |
| AM 91 | RO | 98.5% Porphyrobacter sanguineus | MW970368 | |
| CK 155 | RO | 98.1% Roseomonas sediminicola | MW970369 | |
| CL 63 | RO | 100% Methylorubrum extorquens | MW970370 | |
| BA 23 | RO | 96.2% Methylobacterium indicum | MW970371 | |
| BC100 | RO | 96.6% Sphingomonas yantingensis | MW970372 | |
| CN8 | RO | 99.2% Porphyrobacter neustonensis | MW970373 | |
| GM14 | RO | 99.2% Erythromonas ursincola | MW970374 | |
| Zebra mussels, Lake Winnipeg, MB, Canada | Z1 | RO | 99.1% Porphyrobacter colymbi | MN987006 |
| Z2 | RO | 99.4% Porphyrobacter tepidarius | MN987007 | |
| Z5 | RO | 99.6% Porphyrobacter tepidarius | MN987008 | |
| Z6 | RO | 99.3% Porphyrobacter neustonensis | MN987009 | |
| Z7 | RO | 99.6% Erythromicrobium ramosum | MN987010 | |
| Z24 | RO | 98.7% Porphyrobacter sanguineus | MN987011 | |
| Z27 | RO | 99.4% Porphyrobacter neustonensis | MN987012 | |
| Z39 | RO | 98.9% Porphyrobacter sanguineus | MN987013 | |
| Z59 | RO | 99.5% Porphyrobacter neustonensis | MN987014 | |
| Z68 | RO | 99.4% Porphyrobacter neustonensis | MN987015 |
| Environment | Strain | Medium | Most Related Type Species | Accession # |
|---|---|---|---|---|
| Mahoney Lake, BC, Canada | ML1 | N1 | 98.4% Erythromicrobium ramosum | MW970375 |
| ML3 | N1 | 99.4% Porphyrobacter sanguineus | MW970376 | |
| ML4T | N1 | Porphyrobacter meromictius | NR_115007.1 | |
| ML6T | N1 | Roseicyclus mahoneyensis | NR_042080.1 | |
| ML10 | N1 | 97.9% Salinarimonas ramus | MW970377 | |
| ML14 | N1 | 98.9% Erythromicrobium ramosum | MW970378 | |
| ML19 | N1 | 96.9% Porphyrobacter meromiticus | MW970379 | |
| ML20 | N1 | 99.3% Blastomonas fulva | MW970380 | |
| ML21 | N1 | 98.5% Erythromicrobium ramosum | MW970381 | |
| ML22 | N1 | 99.8% Porphyrobacter sanguineus | MW970382 | |
| ML30 | N1 | 98.8% Seohaeicola saemankumensis | MW970383 | |
| ML35 | N1 | 99.4% Blastomonas fulva | MW970384 | |
| ML36 | N1 | 97.1% Porphyrobacter sanguineus | MW970385 | |
| ML37 | N1 | 95.4% Glycocaulis profundi | MW970386 | |
| ML42 | N1 | 98.0% Roseicyclus marinus | MW970387 | |
| ML45 | N1 | 94.7% Ruegeria intermedia | MW970388 | |
| Blue Lake, BC, Canada | BL1 | BLM | 98.1% Roseicyclus marinus | MW970389 |
| BL4 | BLM | 99.3% Porphyrobacter sanguineus | MW970390 | |
| BL5 | BLM | 99.2% Seohaeicola saemankumensis | MW970391 | |
| BL7 | BLM | 95.6% Glycocaulis profundi | MW970392 | |
| BL8 | BLM | 98.1% Roseicyclus marinus | MW970393 | |
| BL9 | BLM | 98.0% Roseicyclus marinus | MW970394 | |
| BL11 | BLM | 95.8% Glycocaulis profundi | MW970395 | |
| BL14 | BLM | 95.6% Glycocaulis profundi | MW970396 | |
| BL17 | BLM | 95.1% Glycocaulis profundi | MW970397 | |
| BL22 | BLM | 95.0% Glycocaulis profundi | MW970398 | |
| East German Creek System, MB, Canada | EG1 | MA | 95.2% Roseovarius pacificus | AM691094 |
| EG2 | MA | 94.4% Roseovarius bejariae | AM691093 | |
| EG3 | MA | 97.3% Yoonia vestfoldensis | AM691092 | |
| EG4 | MA | 98.8% Erythrobacter longus | AM691105 | |
| EG5 | MA | 95.7% Roseovarius pacificus | AM691095 | |
| EG6 | MA | 98.4% Porphyrobacter meromictius | AM691106 | |
| EG7 | MA | 97.3% Roseovarius nitratireducens | AM691097 | |
| EG8 | MA | 99.0% Roseovarius tolerans | AM691101 | |
| EG9 | MA | 97.3% Roseovarius nitratireducens | AM691098 | |
| EG10 | MA | 98.2% Roseovarius tibetensis | AM691100 | |
| EG11 | MA | 97.7% Roseovarius nitratireducens | AM691099 | |
| EG13 | MA | 99.0% Roseovarius tolerans | AM691102 | |
| EG15 | MA | 98.9% Erythrobacter aquimaris | AM691107 | |
| EG17T | MA | Charonomicrobium ambiphototrophicum | AM691091 | |
| EG19T | MA | Chromocurvus halotolerans | AM691088 | |
| Sandy Lands Forest Soil Crust, MB, Canada | SS56 | BSCA | 99.6% Methylobacterium brachiatum | MW970399 |
| SS63 | BSCA | 99.1% Bosea lupini | MW970400 | |
| SS335 | BSCA | 98.3% Bosea lupini | MW970401 | |
| Spruce Woods National Park Soil Crust, MB, Canada | J01 | BSCA | 98.4% Belnapia moabensis | MW970402 |
| J05 | BSCA | 96.6% Sphingomonas pruni | MW970403 | |
| P4 | BSCB | 99.6% Methylobacterium phyllosphaerae | MW970404 | |
| P13 | BSCB | 98.7% Bosea lupini | MW970405 | |
| P40 | BSCB | 99.9% Belnapia soli | MW970406 | |
| P132 | BSCB | 99.6% Methylobacterium brachiatum | MW970407 | |
| P233 | BSCB | 99.8% Methylobacterium tardum | MW970408 |
References
- Granger, J.; Price, N.M. The importance of siderophores in iron nutrition of heterotrophic marine bacteria. Limnol. Oceanogr. 1999, 44, 541–555. [Google Scholar] [CrossRef]
- Challis, G.L. A widely distributed bacterial pathway for siderophore biosynthesis independent of nonribosomal peptide synthetases. ChemBioChem 2005, 6, 601–611. [Google Scholar] [CrossRef] [PubMed]
- Schalk, I.J.; Hannauer, M.; Braud, A. New roles for bacterial siderophores in metal transport and tolerance. Environ. Microbiol. 2011, 13, 2844–2854. [Google Scholar] [CrossRef] [PubMed]
- Yurkov, V.V.; van Gemerden, H. Impact of light/dark regimen on growth rate, biomass formation and bacteriochlorophyll synthesis in Erythromicrobium hydrolyticum. Arch. Microbiol. 1993, 159, 84–89. [Google Scholar] [CrossRef]
- Yurkov, V.; Hughes, E. Aerobic Anoxygenic Phototrophs: Four Decades of Mystery. In Modern Topics in the Phototrophic Prokaryotes: Environmental and Applied Aspects; Hallenbeck, P.C., Ed.; Springer: Cham, Switzerland, 2017; pp. 193–217. [Google Scholar]
- Faraldo-Gómez, J.D.; Sansom, M.S.P. Acquisition of siderophores in gram-negative bacteria. Nat. Rev. Mol. Cell Biol. 2003, 4, 105–116. [Google Scholar] [CrossRef]
- Lankford, C.E. Bacterial assimilation of iron. Crit. Rev. Microbiol. 1973, 2, 273–331. [Google Scholar] [CrossRef]
- Reid, R.T.; Livet, D.H.; Faulkner, D.J.; Butler, A. A siderophore from a marine bacterium with an exceptional ferric ion affinity constant. Nature 1993, 366, 455–458. [Google Scholar] [CrossRef]
- Wandersman, C.; Delepelaire, P. Bacterial iron sources: From siderophores to hemophores. Annu. Rev. Microbiol. 2004, 58, 611–647. [Google Scholar] [CrossRef]
- Grobelak, A.; Hiller, J. Bacterial siderophores promote plant growth: Screening of catechol and hydroxamate siderophores. Int. J. Phytoremed. 2017, 19, 825–833. [Google Scholar] [CrossRef]
- Crosa, J.H.; Walsh, C.T. Genetics and Assembly Line Enzymology of Siderophore Biosynthesis in Bacteria. Microbiol. Mol. Biol. Rev. 2002, 66, 223–249. [Google Scholar] [CrossRef]
- Lamont, I.L.; Beare, P.A.; Ochsner, U.; Vasil, A.I.; Vasil, M.L. Siderophore-mediated signaling regulates virulence factor production in Pseudomonas aeruginosa. Proc. Natl. Acad. Sci. USA 2002, 99, 7072–7077. [Google Scholar] [CrossRef]
- Adler, C.; Corbalán, N.S.; Seyedsayamdost, M.R.; Pomares, M.F.; de Cristóbal, R.E.; Clardy, J.; Kolter, R.; Vincent, P.A. Catecholate Siderophores Protect Bacteria from Pyochelin Toxicity. PLoS ONE 2012, 7, e46754. [Google Scholar] [CrossRef]
- Ghssein, G.; Brutesco, C.; Ouerdane, L.; Fojcik, C.; Izaute, A.; Wang, S.; Hajjar, C.; Lobinski, R.; Lemaire, D.; Richaud, P.; et al. Biosynthesis of a broad-spectrum nicotianamine-like metallophore in Staphylococcus aureus. Science 2016, 352, 1105–1109. [Google Scholar] [CrossRef]
- Kim, H.J.; Graham, D.W.; DiSpirito, A.A.; Alterman, M.A.; Galeva, N.; Larive, C.K.; Asunskis, D.; Sherwood, P.M.A. Methanobactin, a copper-acquisition compound from methane-oxidizing bacteria. Science 2004, 305, 1612–1615. [Google Scholar] [CrossRef]
- Morey, J.R.; Kehl-Fie, T.E. Bioinformatic Mapping of Opine-Like Zincophore Biosynthesis in Bacteria. mSystems 2020, 5, 1–16. [Google Scholar] [CrossRef]
- Welch, R.M.; Shuman, L. Micronutrient Nutrition of Plants. CRC Crit. Rev. Plant Sci. 1995, 14, 49–82. [Google Scholar] [CrossRef]
- Pedler, J.F.; Parker, D.R.; Crowley, D.E. Zinc deficiency-induced phytosiderophore release by the Triticaceae is not consistently expressed in solution culture. Planta 2000, 211, 120–126. [Google Scholar] [CrossRef]
- Nies, D.H. Heavy metal-resistant bacteria as extremophiles: Molecular physiology and biotechnological use of Ralstonia sp. CH34. Extremophiles 2000, 4, 77–82. [Google Scholar] [CrossRef]
- Rothschild, L.J.; Mancinelli, R.L. Life in extreme environments. Nature 2001, 409, 1092–1101. [Google Scholar] [CrossRef]
- Csotonyi, J.T.; Maltman, C.; Yurkov, V. Influence of tellurite on synthesis of bacteriochlorophyll and carotenoids in aerobic anoxygenic phototrophic bacteria. Res. Trends Photochem. Photobiol. 2014, 16, 1–17. [Google Scholar]
- Maltman, C.; Yurkov, V. The Effect of Tellurite on Highly Resistant Freshwater Aerobic Anoxygenic Phototrophs and Their Strategies for Reduction. Microorganisms 2015, 3, 826–838. [Google Scholar] [CrossRef]
- Csotonyi, J.T.; Swiderski, J.; Stackebrandt, E.; Yurkov, V.V. Novel halophilic aerobic anoxygenic phototrophs from a Canadian hypersaline spring system. Extremophiles 2008, 12, 529–539. [Google Scholar] [CrossRef]
- Csotonyi, J.T.; Stackebrandt, E.; Swiderski, J.; Schumann, P.; Yurkov, V. Chromocurvus halotolerans gen. nov., sp. nov., a gammaproteobacterial obligately aerobic anoxygenic phototroph, isolated from a Canadian hypersaline spring. Arch. Microbiol. 2011, 193, 573–582. [Google Scholar] [CrossRef]
- Drechsel, H.; Jung, G. Peptide siderophores. J. Pept. Sci. 1998, 4, 147–181. [Google Scholar] [CrossRef]
- Yurkov, V. Aerobic Phototrophic Proteobacteria. In The Prokaryotes; Dworkin, M., Falkow, S., Rosenberg, E., Schleifer, K.-H., Stackebrandt, E., Eds.; Springer: New York, NY, USA, 2006; pp. 562–584. [Google Scholar]
- Csotonyi, J.T.; Swiderski, J.; Stackebrandt, E.; Yurkov, V. A new environment for aerobic anoxygenic phototrophic bacteria: Biological soil crusts. Environ. Microbiol. Rep. 2010, 2, 651–656. [Google Scholar] [CrossRef]
- Yurkova, N.; Rathgeber, C.; Swiderski, J.; Stackebrandt, E.; Beatty, J.T.; Hall, K.J.; Yurkov, V. Diversity, distribution and physiology of the aerobic phototrophic bacteria in the mixolimnion of a meromictic lake. FEMS Microbiol. Ecol. 2002, 40, 191–204. [Google Scholar] [CrossRef]
- Kuzyk, S.B.; Pritchard, A.O.; Plouffe, J.; Sorensen, J.L.; Yurkov, V. Psychrotrophic violacein-producing bacteria isolated from Lake Winnipeg, Canada. J. Great Lakes Res. 2020. [Google Scholar] [CrossRef]
- Kuzyk, S.B.; Wiens, K.; Ma, X.; Yurkov, V. Association of aerobic anoxygenic phototrophs and zebra mussels, Dreissena polymorpha, within the littoral zone of Lake Winnipeg. J. Great Lakes Res. 2020. [Google Scholar] [CrossRef]
- Schwyn, B.; Neilands, J.B. Universal chemical assay for the detection and determination of siderophores. Anal. Biochem. 1987, 160, 47–56. [Google Scholar] [CrossRef]
- Rainey, F.A.; Ward-Rainey, N.; Kroppenstedt, R.M.; Stackebrandt, E. The genus Nocardiopsis represents a phylogenetically coherent taxon and a distinct actinomycete lineage: Proposal of Nocardiopsaceae fam. nov. Int. J. Syst. Bacteriol. 1996, 46, 1088–1092. [Google Scholar] [CrossRef]
- Sanger, F.; Coulson, A.R. A rapid method for determining sequences in DNA by primed synthesis with DNA polymerase. J. Mol. Biol. 1975, 94, 441–448. [Google Scholar] [CrossRef]
- Madden, T. The BLAST Sequence Analysis Tool. In The NCBI Handbook [Internet]; McEntyre, J., Ostell, J., Eds.; National Center for Biotechnology Information (US): Bethesda, MD, USA, 2002; pp. 1–15. [Google Scholar]
- Kumar, S.; Stecher, G.; Li, M.; Knyaz, C.; Tamura, K. MEGA X: Molecular evolutionary genetics analysis across computing platforms. Mol. Biol. Evol. 2018, 35, 1547–1549. [Google Scholar] [CrossRef] [PubMed]
- Felsenstein, J. Confidence Limits on Phylogenies: An Approach Using the Bootstrap. Evolution 1985, 39, 783–791. [Google Scholar] [CrossRef] [PubMed]
- Nei, M.; Kumar, S. Molecular Evolution and Phylogenetics; Oxford University Press: New York, NY, USA, 2000. [Google Scholar]
- Barker, R.; Boden, N.; Cayley, G.; Charlton, S.C.; Henson, R.; Holmes, M.C.; Kelly, I.D.; Knowles, P.F. Properties of cupric ions in benzylamine oxidase from pig plasma as studied by magnetic-resonance and kinetic methods. Biochem. J. 1979, 177, 289–302. [Google Scholar] [CrossRef]
- Yamamoto, S.; Okujo, N.; Sakakibara, Y. Isolation and structure elucidation of acinetobactin., a novel siderophore from Acinetobacter baumannii. Arch. Microbiol. 1994, 162, 249–254. [Google Scholar]
- Schägger, H.; von Jagow, G. Tricine-sodium dodecyl sulfate-polyacrylamide gel electrophoresis for the separation of proteins in the range from 1 to 100 kDa. Anal. Biochem. 1987, 166, 368–379. [Google Scholar] [CrossRef]
- Arora, N.K.; Verma, M. Modified microplate method for rapid and efficient estimation of siderophore produced by bacteria. 3 Biotech 2017, 7, 1–9. [Google Scholar] [CrossRef]
- Ames-Gottfred, N.P.; Christie, B.R.; Jordan, D.C. Use of the Chrome Azurol S Agar Plate Technique to Differentiate Strains and Field Isolates of Rhizobium leguminosarum biovar trifolii. Appl. Environ. Microbiol. 1989, 55, 707–710. [Google Scholar] [CrossRef]
- Amaro, C.; Aznar, R.; Alcaide, E.; Lemos, M.L. Iron-binding compounds and related outer membrane proteins in Vibrio cholerae non-O1 strains from aquatic environments. Appl. Environ. Microbiol. 1990, 56, 2410–2416. [Google Scholar] [CrossRef]
- Patel, P.R.; Shaikh, S.S.; Sayyed, R.Z. Modified chrome azurol S method for detection and estimation of siderophores having affinity for metal ions other than iron. Environ. Sustain. 2018, 1, 81–87. [Google Scholar] [CrossRef]
- Rensing, C.; Ghosh, M.; Rosen, B.P. Families of Soft-Metal-Ion-Transporting ATPases. J. Bacteriol. 1999, 181, 5891–5897. [Google Scholar] [CrossRef]
- Idris, R.; Trifonova, R.; Puschenreiter, M.; Wenzel, W.W.; Sessitsch, A. Bacterial communities associated with flowering plants of the Ni hyperaccumulator Thlaspi goesingense. Appl. Environ. Microbiol. 2004, 70, 2667–2677. [Google Scholar] [CrossRef]
- Sun, L.N.; Zhang, Y.F.; He, L.Y.; Chen, Z.J.; Wang, Q.Y.; Qian, M.; Sheng, X.F. Genetic diversity and characterization of heavy metal-resistant-endophytic bacteria from two copper-tolerant plant species on copper mine wasteland. Bioresour. Technol. 2010, 101, 501–509. [Google Scholar] [CrossRef]
- Maltman, C.; Donald, L.; Yurkov, V. Tellurite and Tellurate Reduction by the Aerobic Anoxygenic Phototroph Erythromonas ursincola, Strain KR99 Is Carried out by a Novel Membrane Associated Enzyme. Microorganisms 2017, 5, 20. [Google Scholar] [CrossRef]
- Atkin, C.L.; Neilands, J.B. Rhodotorulic Acid, a Diketopiperazine Dihydroxamic Acid with Growth-Factor Activity. I. Isolation and Characterization. Biochemistry 1968, 7, 3734–3739. [Google Scholar] [CrossRef]
- Andersen, D.; Renshaw, J.C.; Wiebe, M.G. Rhodotorulic acid production by Rhodotorula mucilaginosa. Mycol. Res. 2003, 107, 949–956. [Google Scholar] [CrossRef]
- Carson, K.C.; Meyer, J.M.; Dilworth, M.J. Hydroxamate siderophores of root nodule bacteria. Soil Biol. Biochem. 2000, 32, 11–21. [Google Scholar] [CrossRef]
- Holinsworth, B.; Martin, J.D. Siderophore production by marine-derived fungi. BioMetals 2009, 22, 625–632. [Google Scholar] [CrossRef]
- Mihara, K.; Tanabe, T.; Yamakawa, Y.; Funahashi, T.; Nakao, H.; Narimatsu, S.; Yamamoto, S. Identification and transcriptional organization of a gene cluster involved in biosynthesis and transport of acinetobactin, a siderophore produced by Acinetobacter baumannii ATCC 19606T. Microbiology 2004, 150, 2587–2597. [Google Scholar] [CrossRef]
- Goeker, M. The One Thousand Microbial Genomes Phase 4 Project (KMG-4) Sequencing the Most Valuable Type-Strain Genomes for Metagenomic Binning, Comparative Biology and Taxonomic Classification; DOE Joint Genome Institute: Oak Ridge, TN, USA, 2016. [CrossRef]




| Environment | Strain | Medium | Mg | V | Mn | Fe | Co | Ni | Cu | Zn | Se | Te |
|---|---|---|---|---|---|---|---|---|---|---|---|---|
| Hot spring, Kamchatka Isl. | KR99T | RO | ++ | +++ | ++ | +++ | ++ | ++ | ++ | +++ | ++ | +++ |
| Warm temperature spring, Baikal Lake, Russia | E1 | RO | − | − | + | ++ | + | + | − | − | − | − |
| E4(1) | RO | − | − | − | ++ | − | − | − | − | − | + | |
| E5T | RO | − | − | − | + | − | − | − | − | − | + | |
| RB3T | RO | − | − | ++ | ++ | − | ++ | + | + | + | + | |
| RB16-17T | RO | − | − | − | + | − | − | + | − | − | − | |
| T4T | RO-NaCl | + | + | + | − | + | + | − | − | + | + | |
| Deep Ocean, Juan De Fuca Ridge, Pacific Ocean | JF1T | RO-NaCl | + | + | + | + | + | + | + | + | + | + |
| C6 | RO-NaCl | + | + | + | + | + | + | + | + | + | + | |
| C7 | RO-NaCl | + | + | + | + | − | + | + | + | + | + | |
| C8 | RO-NaCl | + | + | + | + | − | + | + | + | + | + | |
| C14 | RO-NaCl | + | + | + | + | − | + | + | + | + | + | |
| C23 | RO-NaCl | − | + | + | + | + | + | + | + | + | + | |
| C26 | RO-NaCl | + | + | + | + | + | + | + | + | + | + | |
| N25 | RO-NaCl | + | + | + | + | + | + | + | + | + | + | |
| N34 | RO-NaCl | + | + | + | + | + | + | + | + | + | + | |
| N48 | RO-NaCl | + | + | + | + | + | + | + | + | + | + | |
| N56 | RO-NaCl | + | + | + | + | + | + | + | + | + | + | |
| N78 | RO-NaCl | + | + | + | + | + | + | + | + | + | + | |
| Rag Beach sediment, BC, Canada | 15-SB | RO-NaCl | + | − | + | + | − | − | + | + | + | + |
| 23-SB | RO-NaCl | + | − | + | + | + | + | − | + | − | − | |
| Central Gold Mine, MB, Canada | C4 | RO | − | + | + | + | + | + | + | + | − | + |
| C9 | RO | − | + | − | + | + | − | + | + | − | + | |
| C11 | RO | − | + | − | + | − | − | + | + | − | − | |
| NM4.16 | RO | − | + | + | ++ | + | + | + | + | − | + | |
| NM4.18 | RO | ++ | + | + | ++ | ++ | ++ | ++ | + | ++ | ++ | |
| Lake Winnipeg, MB, Canada | AJ 72 | RO | − | + | + | +++ | + | + | + | ++ | − | + |
| AM 19 | RO | − | + | − | +++ | − | − | − | ++ | − | − | |
| AM 27 | RO | − | − | − | ++ | − | − | − | + | − | − | |
| AM 91 | RO | − | − | − | - | − | − | − | − | − | − | |
| BA 23 | RO | + | ++ | ++ | ++ | ++ | + | ++ | ++ | ++ | ++ | |
| BC 100 | RO | − | − | − | ++ | + | − | − | − | − | − | |
| BE 100 | RO | ++ | ++ | ++ | +++ | ++ | ++ | ++ | ++ | ++ | + | |
| BK 61 | RO | + | + | + | +++ | + | − | + | ++ | + | − | |
| BL 67 | RO | − | − | − | − | + | − | − | − | − | − | |
| CK 155 | RO | − | − | − | ++ | − | − | − | − | − | − | |
| CK 182 | RO | − | − | − | − | − | − | − | − | − | − | |
| CL 63 | RO | + | ++ | ++ | ++ | ++ | ++ | ++ | ++ | ++ | ++ | |
| CN8 | RO | + | ++ | + | ++ | + | + | − | ++ | ++ | + | |
| GM14 | RO | ++ | ++ | ++ | +++ | ++ | + | − | ++ | ++ | + | |
| Zebra mussels, Lake Winnipeg, MB, Canada | Z1 | RO | − | − | − | + | − | − | − | − | − | − |
| Z2 | RO | − | − | − | − | − | − | − | − | − | − | |
| Z5 | RO | − | − | − | − | − | − | − | − | − | − | |
| Z6 | RO | + | − | + | − | + | + | − | − | + | − | |
| Z7 | RO | + | − | − | − | − | − | − | − | − | − | |
| Z24 | RO | − | − | − | ++ | − | − | − | + | - | − | |
| Z27 | RO | + | + | + | ++ | − | − | − | ++ | + | ++ | |
| Z39 | RO | − | − | + | ++ | + | − | − | + | − | − | |
| Z59 | RO | + | − | + | + | − | + | − | − | + | − | |
| Z68 | RO | − | ++ | − | ++ | − | + | − | ++ | − | + |
| Environment | Strain | Medium | Mg | V | Mn | Fe | Co | Ni | Cu | Zn | Se | Te |
|---|---|---|---|---|---|---|---|---|---|---|---|---|
| Mahoney Lake, BC, Canada | ML1 | N1 | − | + | − | + | − | − | + | + | − | + |
| ML3 | N1 | − | + | − | + | − | − | + | + | − | + | |
| ML4T | N1 | − | + | − | + | − | − | + | + | − | + | |
| ML6T | N1 | + | + | + | + | − | − | + | + | − | + | |
| ML10 | N1 | − | + | − | + | − | − | + | + | − | + | |
| ML14 | N1 | − | + | − | + | − | − | + | + | − | + | |
| ML19 | N1 | + | + | + | + | + | − | + | + | + | + | |
| ML20 | N1 | − | + | − | + | − | − | + | + | − | + | |
| ML21 | N1 | − | + | − | + | − | − | + | + | − | + | |
| ML22 | N1 | − | + | + | + | − | − | + | + | − | + | |
| ML30 | N1 | + | + | − | + | − | − | + | + | + | + | |
| ML35 | N1 | − | + | − | + | − | − | + | + | − | + | |
| ML36 | N1 | + | + | + | + | + | − | + | + | + | + | |
| ML37 | N1 | − | + | + | + | − | − | + | + | − | + | |
| ML42 | N1 | + | + | + | + | + | + | + | + | + | + | |
| ML45 | N1 | + | + | + | + | − | + | + | + | + | + | |
| Blue Lake, BC, Canada | BL1 | BLM | + | + | + | + | + | + | + | + | + | + |
| BL4 | BLM | − | + | − | + | − | − | + | + | − | + | |
| BL5 | BLM | + | + | + | + | + | + | + | + | + | + | |
| BL7 | BLM | + | + | + | − | + | + | + | − | + | + | |
| BL8 | BLM | + | + | + | + | + | + | + | + | + | + | |
| BL9 | BLM | + | + | + | + | + | + | + | + | + | + | |
| BL11 | BLM | + | + | + | − | + | + | + | + | + | + | |
| BL14 | BLM | + | + | + | − | + | + | + | + | + | + | |
| BL17 | BLM | + | + | + | + | + | + | + | + | + | + | |
| BL22 | BLM | + | − | + | − | + | + | + | − | + | + | |
| East German Creek System, MB, Canada | EG1 | MA | − | + | − | + | − | − | + | + | − | + |
| EG2 | MA | + | + | + | + | − | − | + | + | − | + | |
| EG3 | MA | − | - | − | + | − | − | − | − | − | − | |
| EG4 | MA | − | + | − | + | − | − | + | + | − | + | |
| EG5 | MA | − | + | + | + | − | − | + | + | − | + | |
| EG6 | MA | − | + | − | + | − | − | + | + | − | + | |
| EG7 | MA | − | + | + | + | − | − | + | + | − | + | |
| EG8 | MA | − | + | − | + | + | − | + | + | + | + | |
| EG9 | MA | − | + | − | + | − | − | + | + | − | + | |
| EG10 | MA | − | + | − | + | − | − | + | + | + | + | |
| EG11 | MA | − | + | − | + | − | − | + | + | − | + | |
| EG13 | MA | − | + | − | + | − | − | + | + | − | + | |
| EG15 | MA | − | + | − | + | + | − | + | + | − | + | |
| EG17T | MA | + | + | + | + | + | + | + | + | − | + | |
| EG19T | MA | + | + | + | ++ | − | + | + | ++ | + | + | |
| Sandy Lands Forest soil crust, MB, Canada | SS56 | BSCA | ++ | ++ | ++ | + | ++ | ++ | ++ | ++ | ++ | ++ |
| SS63 | BSCA | ++ | +++ | ++ | +++ | ++ | +++ | +++ | +++ | +++ | +++ | |
| SS335 | BSCA | +++ | +++ | +++ | +++ | ++ | ++ | +++ | ++ | ++ | +++ | |
| Spruce Woods National Park soil crust, MB, Canada | J01 | BSCA | +++ | ++ | +++ | +++ | + | ++ | ++ | ++ | + | ++ |
| J05 | BSCA | + | + | + | ++ | − | − | + | + | − | + | |
| P4 | BSCB | ++ | ++ | ++ | + | + | + | ++ | ++ | ++ | ++ | |
| P13 | BSCB | +++ | +++ | +++ | +++ | ++ | +++ | +++ | +++ | ++ | ++ | |
| P40 | BSCB | ++ | ++ | ++ | ++ | + | ++ | ++ | ++ | + | + | |
| P132 | BSCB | ++ | ++ | ++ | +++ | ++ | ++ | ++ | ++ | ++ | ++ | |
| P233 | BSCB | − | ++ | ++ | +++ | ++ | ++ | ++ | ++ | ++ | ++ |
Publisher’s Note: MDPI stays neutral with regard to jurisdictional claims in published maps and institutional affiliations. |
© 2021 by the authors. Licensee MDPI, Basel, Switzerland. This article is an open access article distributed under the terms and conditions of the Creative Commons Attribution (CC BY) license (https://creativecommons.org/licenses/by/4.0/).
Share and Cite
Kuzyk, S.B.; Hughes, E.; Yurkov, V. Discovery of Siderophore and Metallophore Production in the Aerobic Anoxygenic Phototrophs. Microorganisms 2021, 9, 959. https://doi.org/10.3390/microorganisms9050959
Kuzyk SB, Hughes E, Yurkov V. Discovery of Siderophore and Metallophore Production in the Aerobic Anoxygenic Phototrophs. Microorganisms. 2021; 9(5):959. https://doi.org/10.3390/microorganisms9050959
Chicago/Turabian StyleKuzyk, Steven B., Elizabeth Hughes, and Vladimir Yurkov. 2021. "Discovery of Siderophore and Metallophore Production in the Aerobic Anoxygenic Phototrophs" Microorganisms 9, no. 5: 959. https://doi.org/10.3390/microorganisms9050959
APA StyleKuzyk, S. B., Hughes, E., & Yurkov, V. (2021). Discovery of Siderophore and Metallophore Production in the Aerobic Anoxygenic Phototrophs. Microorganisms, 9(5), 959. https://doi.org/10.3390/microorganisms9050959





